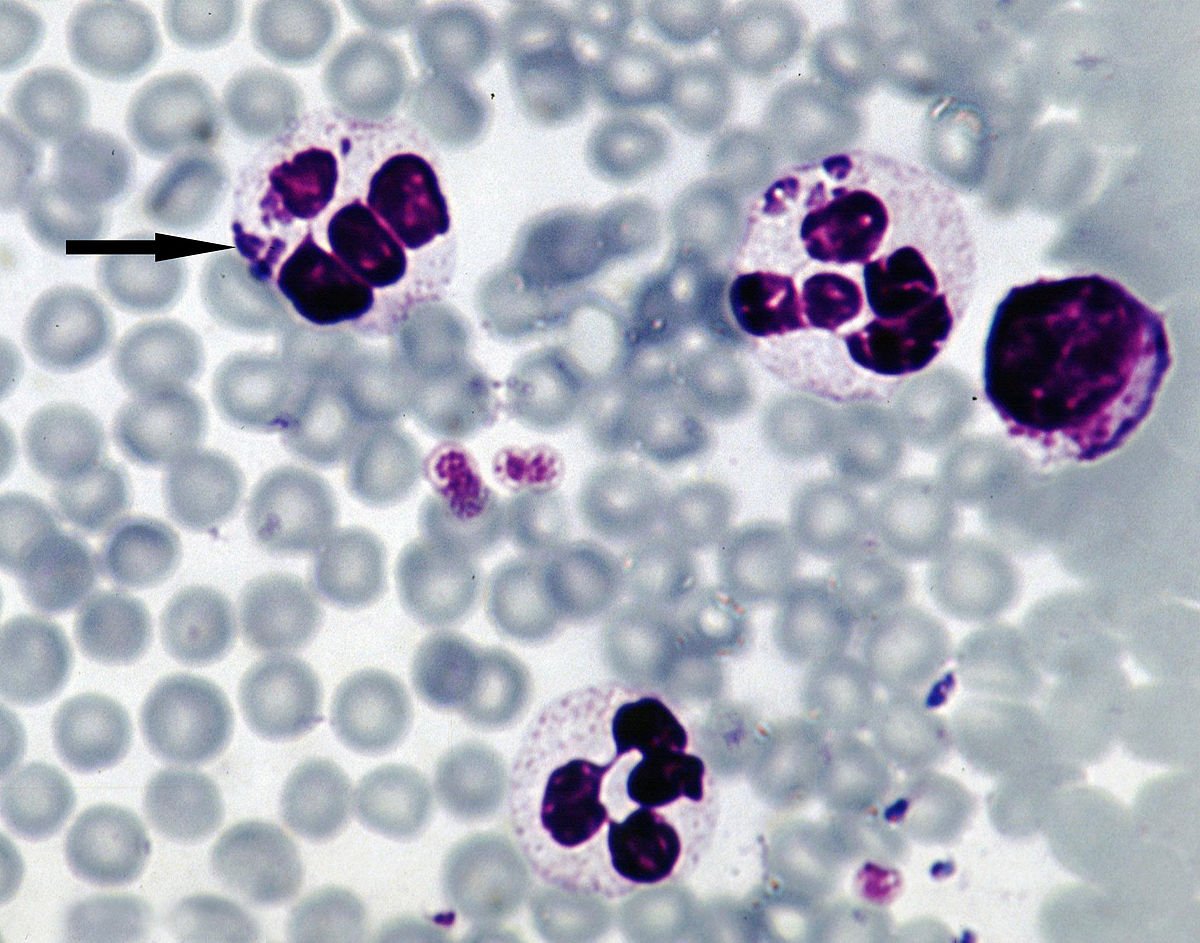
omarsery1's tweet image. #Klíšťata přenášejí i jiné choroby, např. #Anaplasma phagocytophilum, která způsobuje do týdne horečky a je léčitelná pouze doxycyklinem

#anaplasma search results
3 #LymeDisease coinfections, Ehrlichia, #Anaplasma & Rocky Mountain spotted fever, are caused by similar types of Rickettsial bacteria & have a strong chance of contributing to severe, life-threatening symptoms. #Ehrlichia #RMSF Read more: projectlyme.org/resource/ehrli…
ACTUALIZACIÓN #NOA. La veterinaria Jpets envía este estado de cuenta, faltan $523.000 para completar para la cirugía. Sin tener en cuenta los medicamentos y el tratamiento para el #anaplasma y al parecer tiene un herpes en su boquita. De #Niña falta su atención médica de nuevo🥺

Toxicosis in human and domestic hosts caused by ixodid #ticks detected with #Anaplasma platys and Hepatozoon ayorgbor dlvr.it/TNR1cB #ActaTropica

🧬A simple and reproducible method to estimate Anaplasma phagocytophilum numbers using McFarland standards is now available! This approach facilitates in vitro infection studies of obligate intracellular bacteria. 🔗 mdpi.com/2076-2607/13/3… #Anaplasma #Microbiology

#7: Tick of the day. Deer tick from Erie County, New York. #deertick #anaplasmosis #anaplasma #ticktesting

#9 Tick of the day: Ixodes scapularis from Connecticut. We detected 3 pathogens from this single tick: #Borrelia burgdorferi, #Anaplasma phagocytophilum, and #Babesia microti.

📢 Not Only Leptotrombidium spp. an Annotated Checklist of Chigger #Mites (Actinotrichida: Trombiculidae) Associated with #BacterialPathogens 👨🎓 by Hanna Moniuszko et al. 🔗 Full article: mdpi.com/2076-0817/11/1… #Anaplasma #Bartonella #Borrelia #Coxiella #Francisella #Leptospira

📢 Detection of #TickBorne Pathogens of the Genera #Rickettsia, #Anaplasma and #Francisella in #Ixodes ricinus #Ticks in Pomerania (Poland) 👨🎓 by Lucyna Kirczuk et al. 🔗 mdpi.com/2076-0817/10/7… 👉 Special Issue: Ticks and Tick-Borne Diseases―Pathogens, Parasites and People

Presence of #Anaplasma phagocytophilum Ecotype I in UK Ruminants and Associated #Zoonotic Risk ✏️by Laura Bianchessi et al. 👉Full-Text mdpi.com/2076-0817/12/2… #TickBornePathogen #OneHealth

FIV + FeLV,CPV, CDV, CHW,Babesia, Anaplasma, Rapid Test... We have all the products you care about for your pet's. #veterinary #ColloidalGold #Babesia #Anaplasma#CHW #FeLV #pet #Vet


Journal of Basic Medical Veterinary (JBMV) present the paper by Febriyatin, et al. on Occurrence of Anaplasma sp. infection in pigs (Sus scrofa) at Morgan Farm, Palangka Raya City #anaplasma #pigs
Molecular detection and associated risk factors of #Anaplasma marginale, A. ovis and A. platys in sheep from Algeria with evidence of the absence of A. phagocytophilum dlvr.it/SxRpHY #ActaTropica

ACTUALIZACIÓN #NOA. La veterinaria Jpets envía este estado de cuenta, faltan $523.000 para completar para la cirugía. Sin tener en cuenta los medicamentos y el tratamiento para el #anaplasma y al parecer tiene un herpes en su boquita. De #Niña falta su atención médica de nuevo🥺

Wild Small Mammals and #Ticks in Zoos—Reservoir of Agents with #Zoonotic Potential? ✏️by Pavlína Pittermannová et al. 👉Full-Text mdpi.com/2076-0817/10/6… #Anaplasma #Borrelia #Coxiella

Unravelling the diversity of #Anaplasma species circulating in selected African wildlife hosts by targeted 16S #microbiome analysis sciencedirect.com/science/articl… #OpenAccess #Ehrlichia

The tick-borne infection #Anaplasma may cause conduction problems and inflammation of the heart muscle — symptoms frequently associated with #LymeDisease — according to this case study of a 65-year-old Boston man. More via @DrDanielCameron #heartmonth danielcameronmd.com/can-anaplasmos…

#Maine reports more than 3,000 #Lymedisease cases in 2024 #Anaplasma #babesia #ticks open.substack.com/pub/outbreakne…

New in @CRPVBD Results of the largest seroprevalence survey in apparently healthy dogs assessing the geographical distribution of four CVBD in Mexico sciencedirect.com/science/articl… #Ehrlichia #Anaplasma #Borrelia #Dirofilaria

📢 Molecular and Serological Identification of #Anaplasma marginale and #Borrelia burgdorferi in Cattle and #Ticks from Nuevo Leon, Northern Mexico 👨🎓by José Ángel Ortiz-Ramírez et al. @uanl 🔗mdpi.com/2076-0817/12/6… #tickBorne

🧬A simple and reproducible method to estimate Anaplasma phagocytophilum numbers using McFarland standards is now available! This approach facilitates in vitro infection studies of obligate intracellular bacteria. 🔗 mdpi.com/2076-2607/13/3… #Anaplasma #Microbiology

Molecular detection and genetic diversity of #Anaplasma and Ehrlichia species in livestock and dogs in Pakistan dlvr.it/TLPgJl #ActaTropica
Special issue on intracellular bacteria. #Chlamydia #Rickettsia #Anaplasma #Bartonella sciencedirect.com/journal/microb…

Tick-borne pathogen detection: What’s new? sciencedirect.com/science/articl… #Anaplasma #Borrelia #Rickettsia #Babesia #LymeDisease #ticks

2/5 @AlexanderGofton presents his novel #neoehrlichia #anaplasma & #ehrlichia spp research @ #VLSposterday16 @VetLifeScience @MUniResearch

Distinguishing features of different tick species #LymeDisease #lyme #anaplasma #babesia #outdoorlife #education #safety #diseases #ticks

Chlamydiales, #Anaplasma and #Bartonella: persistence and immune escape of intracellular bacteria sciencedirect.com/science/articl… #chlamydia #immunology

Chlamydiales, #Anaplasma and #Bartonella: Persistence and immune escape of intracellular bacteria. sciencedirect.com/science/articl… #Chlamydia #openaccess

Blood smear shows #Anaplasma which, with #Lyme #Disease #Babesiosis is transmitted by ticks. Photo courtesy #BSG.

Read the latest issue of The Lyme Times a Special Issue on Tick-Borne Co-infections. #Anaplasma #Babesia #LymeDisease #Rickettsia #Powassan and more... lymedisease.org/members/lyme-t…

Tick-borne pathogen detection: What’s new? sciencedirect.com/science/articl… #ticks #Anaplasma #Borrelia #Rickettsia #LymeDisease

1800 in a YEAR? There's no way I'm that rare @CDCgov #GrosslyUnderreported #Anaplasma #Anaplasmosis #TBI #TBD

#Anaplasma red blood cell parasite, coinfection of #Lymedisease, can be fatal. Sign/share change.org/p/barack-obama…

The incidence of tick-borne Anaplasmosis is increasing. Here's what you need to know. #Anaplasma #LymeDisease lymedisease.org/lyme-sci-anapl…

#Klíšťata přenášejí i jiné choroby, např. #Anaplasma phagocytophilum, která způsobuje do týdne horečky a je léčitelná pouze doxycyklinem
My new study on pathogen-vector interaction is online now. Full text available at 👇 parasitesandvectors.biomedcentral.com/articles/10.11… @alex_maslin @ticklab @pascoeel @Caitlin07554129 @WhatDoBirdsEat @BugsPhil @maxwellidae @areyoukeddingme @m_nazarbeigy @MondragonShem #ticks #anaplasma

#7: Tick of the day. Deer tick from Erie County, New York. #deertick #anaplasmosis #anaplasma #ticktesting

#Anaplasma phagocytophilum infection in moose (Alces alces) in Norway sciencedirect.com/science/articl…


#Pathogens Manipulating #Tick Behavior—Through a Glass, Darkly 👉by Giovanni Benelli 📌Full-Text mdpi.com/2076-0817/9/8/… #Anaplasma #Babesia #Bartonella #Borrelia

Please suggest an online tool or software for designing a schematic diagram showing the infection cycle. Thanks in advance @GlobalVectorHub #ticks #Anaplasma

Something went wrong.
Something went wrong.
United States Trends
- 1. #BaddiesUSA 62.6K posts
- 2. TOP CALL 3,483 posts
- 3. Rams 29.7K posts
- 4. #LAShortnSweet 22.7K posts
- 5. #centralwOrldXmasXFreenBecky 346K posts
- 6. SAROCHA REBECCA DISNEY AT CTW 362K posts
- 7. Scotty 10.1K posts
- 8. AI Alert 1,070 posts
- 9. Chip Kelly 8,870 posts
- 10. #LingOrmDiorAmbassador 185K posts
- 11. sabrina 64.5K posts
- 12. #ITWelcomeToDerry 16.2K posts
- 13. Market Focus 2,339 posts
- 14. Vin Diesel 1,390 posts
- 15. Raiders 68.5K posts
- 16. Stacey 25K posts
- 17. Ahna 7,499 posts
- 18. billie 20.1K posts
- 19. Check Analyze N/A
- 20. Token Signal 1,484 posts



























